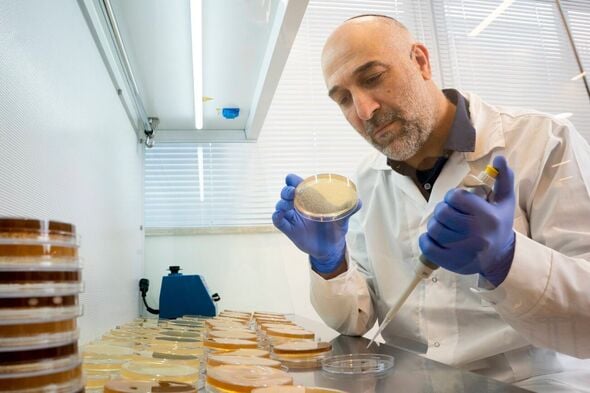
צילום מתוך דף הפייסבוק הפקולטה לחקלאות,

ד"ר אביהוא יונה מהפקולטה לחקלאות ברחובות זכה במענק מחקר בסך 500,000 ש"ח לפיתוח בדיקה חדשנית לאבחון אי-סבילות למזון
ד"ר אביהוא יונה מהמכון לביוכימיה, מדעי המזון והתזונה בפקולטה לחקלאות ברחובות, זכה במענק מחקר בסך 500,000 ש"ח מטעם משרד החדשנות, המדע והטכנולוגיה.
המענק נועד לתמוך בפיתוח בדיקה חדשנית המבוססת על דגימת צואה לאבחון אי-סבילות למזון, אשר תשמש כחלופה לבדיקת הנשיפה הארוכה הנהוגה כיום. השיטה החדשה תחסוך למטופלים ביקורים ממושכים במרפאה ושהייה תחת פיקוח רפואי במשך שעות, שכן היא מסתמכת על דגימת צואה אחת בלבד.
במסגרת הבדיקה החדשה, מרכיב המזון החשוד מתווסף לדגימה, והגז הנוצר על ידי חיידקי המעי נמדד. גישה זו מאפשרת בדיקה של מספר חומרים בו-זמנית, בצורה פשוטה, נגישה וזולה יותר. הפיתוח צפוי להנגיש את בדיקות האבחון לאי-סבילות למזון ולייעל את הפרקטיקות הרפואיות הקיימות בתחום.

להצטרפות לוואטסאפ חדשות רחובות להצטרפות לקבוצת וואטסאפ ששולחת דילים וקופונים לאליאקספרס
באתר זה שולבו סרטונים, תמונות ומידע מהרשתות החברתיות בשימוש לפי סעיף 27א לחוק זכויות יוצרים. במידה וידוע מי צילם שלחו למייל בקשה לצרף קרדיט או להסרה

- אורחכל הכבוד ישר כח06.01.26 10:25 תגובה
- אורחהלוואי שייצא לפועל06.01.26 11:05 תגובה
- אורחיפה מאוד07.01.26 01:22 תגובה

מנסה לטעון שוב
הצטרפו אלינו!
הצטרפו לקבוצות הוואטסאפ שלנו:
אפליקציה בחנות האפליקציות: